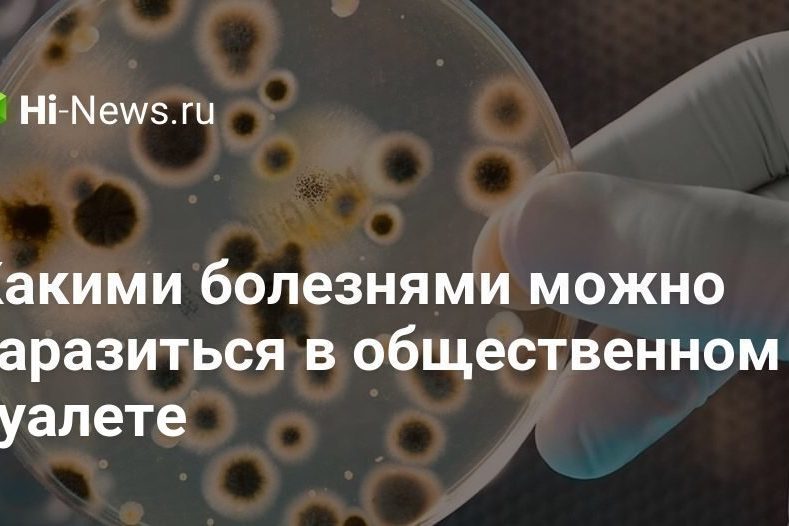
Какими болезнями можно заразиться в общественном туалете

Содержание статьи
- 1 Что нового в macOS Ventura: все новые функции
- 2 Угроза Anonymous в адрес главы Terra: новости крипторынка От Investing.com
- 3 Какими болезнями можно заразиться в общественном туалете
- 4 Apple готовит новые MacBook Pro с чипами M2 Pro и M2 Max
- 5 Из-за Солнца спутники начали падать на Землю в 10 раз быстрее » 24Gadget.Ru :: Гаджеты и технологии
- 6 Тим Кук намекнул на грядущий анонс AR-устройства
- 7 Генератор QR-кодов «ВКонтакте», или как создавать крутые QR-коды с собственным дизайном
- 8 Сравнение MacBook Pro 13″ M2 с MacBook Pro 14″ и 16″ (2021)
Что нового в macOS Ventura: все новые функции
На WWDC 2022 Apple анонсировала новую операционную систему для Mac под названием macOS Ventura. С macOS Monterey Apple сосредоточилась на улучшении системных приложений, а в macOS Ventura переключила внимание на приложение «Почта», улучшение Spotlight и многозадачности с функцией Stage Manager, а также Continuity Camera для использования iPhone в качестве веб-камеры. В статье собрали все новые функции…